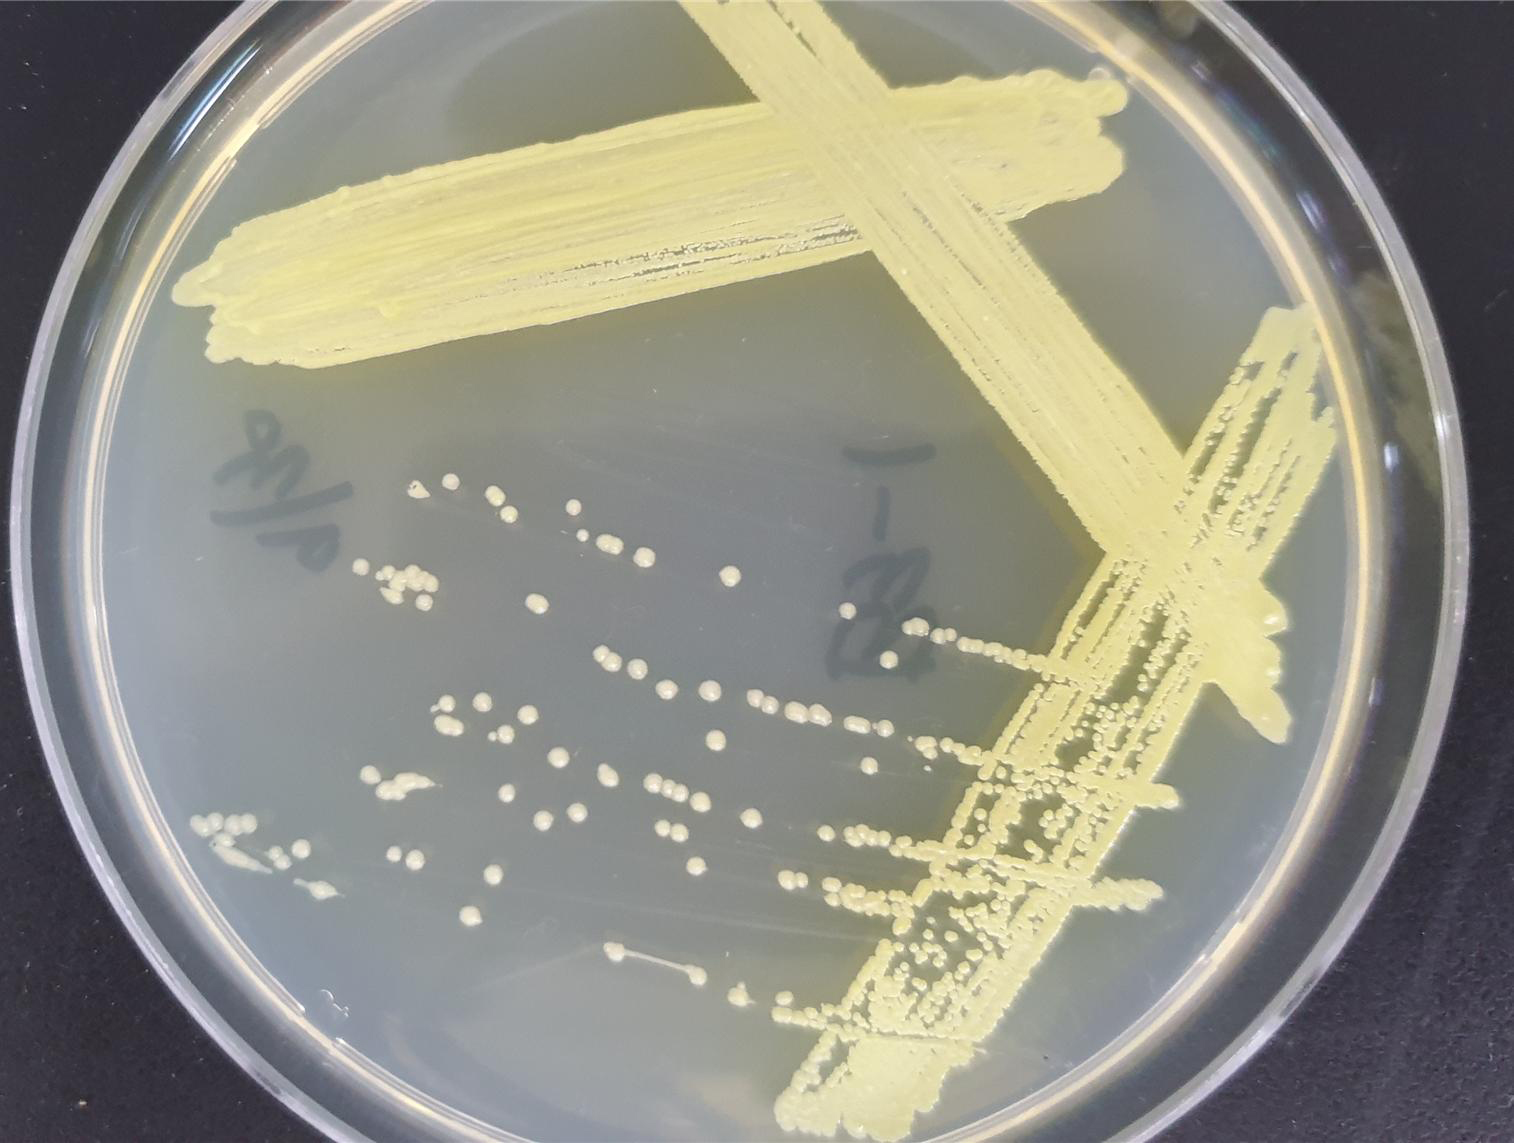

사진으로 보는 군정
-

- 자동차세 연세액 납부하면 10% 공제
- 순창군은 오는 31일까지 자동차세 연납신청을 받는다. 자동차세 연납신청은 매년 6월과 12월에 연 2회 납부하는 세금을 1월에 연납하면 10%, 3월에 연납하면 7.5%, 6월에 연납하면 5%, 9월에 연납하면 2.5%가 공제된 금액으로 자동차세를 납부하는 제도이다. -2020년 1월 3일-
- 담당부서 : 기획예산실
- 작성일 : 2020-01-03
-
- 순창군 토종미생물 1종 특허 출원
- 순창군이 농작물 병해 방제 활성을 갖는 우수 토착미생물에 대한 특허를 출원했다. 순창군 토양으로부터 10종의 항균활성을 갖는 미생물을 발견하고, 이 중에서 기능이 뛰어난 1종을 선별하여 실험을 마친 끝에 최근 특허를 출원했다. 이번에 특허를 출원한 1종의 미생물은 버크홀데리아 속 균주(Burkholeria territorii SCAT001)이며 농작물의 병해를 일으키는 병원균에 대한 억제 활성률이 높은 것으로 나타났다. 농업기술센터는 특허로 출원한 미생물을 특허균주(KACC92280P)로 등록했으며, 다양한 분야의 활용을 위한 심화연구를 현재 수행하고 있다. -2020년 1월 3일-
- 담당부서 : 기획예산실
- 작성일 : 2020-01-03
-

- 순창 동계초 졸업식
- 순창 동계초등학교(교장 박진현)는 3일 제97회 졸업식이 시청각실에서 11명이 졸업생과 선생님, 동계면 기관사회단체장, 학부모 등 100여명이 참석한 가운데 열렸다. 2020년 순창에서 첫 졸업식이 열린 이날 11명의 학생들은 선생님과 함께 마지막 추억을 담으며 환하게 웃고 있다. -2020년 1월 3일-
- 담당부서 : 기획예산실
- 작성일 : 2020-01-03
-

- 소식재배이앙기 개조사업 추진
- 순창군이 올해 농업인들의 농기계 구입 부담을 줄이고 농업생산성을 높인다는 취지에서 `소식재배 이양기 개조사업`으로 20대를 지원한다. 사업비 2천 1백만원이 투입되는 이 사업은 이앙기 개조비의 70%를 지원하는 것으로 순창군 자체사업으로 추진할 예정이다. -2020년 1월 3일-
- 담당부서 : 기획예산실
- 작성일 : 2020-01-03
-

- 순창군 홈페이지로 새단장
- 순창군이 대표홈페이지를 새단장하여 3일부터 본격 서비스를 시작한다. 지난해 5월부터 ‘스마트 통합 홈페이지 구축 사업’을 추진하여 순창군에서 운영 중인 주요 홈페이지를 통합하고, ‘반응형 웹’으로 전면 개편했다. 반응형 웹은 스마트폰, 태블릿, PC 등 어느 기기에서든 기기에 맞게 자동으로 최적화된 크기로 디자인이 변경되어 동일한 내용을 볼 수 있는 기술로 이용자가 원하는 정보를 편리하고 빠르게 접근할 수 있도록 했다. -2020년 1월 3일-
- 담당부서 : 기획예산실
- 작성일 : 2020-01-03
-

- 2019년 순창군 시무식
- 황숙주 순창군수는 2일 군청 회의실에서 300여명의 직원들이 참석한 가운데 순창군 시무식을 갖고 새해 순창비전을 제시하며 힘찬 출발을 다짐했다. 이날 황군수는 “올해는 `군민보다 먼저 근심하고, 나중에 즐긴다`는 선우후락(先憂後樂)의 자세로 군민의 행복과 군정 발전을 최우선 과제로 삼고 시대 변화에 발맞춰 정진해 나가겠다”라고 다짐했다. -2020년 1월 2일-
- 담당부서 : 기획예산실
- 작성일 : 2020-01-03
-

- 황숙주 군수, 현충탑 참배
- 황숙주 군수는 2일 전해성 부군수 및 간부들과 함께 충혼탑을 찾아 순국선열과 호국영령의 숭고한 희생정신을 기리며 순창발전의 각오를 다짐했다. -2020년 1월 2일-
- 담당부서 : 기획예산실
- 작성일 : 2020-01-03
-

- 제26대 전해성 순창군 부군수 취임식
- 전해성(57, 사진) 전라북도 혁신성장정책과장이 2일 순창부군수로 취임했다. 신임 전 부군수는 1991년 총무처 7급 공채를 시작으로 법제처, 전주시 우아1동장, 경제교통과장, 진안군 백운면장, 전략산업과장, 환경보호과장, 전북도 투자유치과장, 일자리경제정책관, 혁신성장정책과장 등 전북도내 주요 요직을 두루 거쳤다. -2020년 1월 2일-
- 담당부서 : 기획예산실
- 작성일 : 2020-01-03
-

- 새해 소망을 염원하는 해맞이 행사
- 1일 순창읍 금산, 구림면 회문산, 팔덕면 강천산 등 2020년 새해맞이 `해맞이 행사`가 순창군 곳곳에서 열렸다. 또 복흥면 추월산 밀재와 동계면 어치 느재, 쌍치면 방산마을 망태봉 등에서도 소망을 빌며 해맞이를 하고 떡국을 나눠 먹으며 주민화합을 다짐했다. -2020년 1월 1일-
- 담당부서 : 기획예산실
- 작성일 : 2020-01-03
-

- 2020년 금산 일출
- 순창군은 2020년을 맞이하는 사자성어를 「선우후락(先憂後樂)」으로 정했다.오늘 첫발을 내디딘 새해의 출발선에서 전 공직자는“군민보다 먼저 근심하고, 나중에 즐긴다”는 선우후락의 자세로 군민의 행복과 군정 발전을 최우선 과제로 시대의 변화에 맞춰 정진해 나가겠습니다.선우후락(先憂後樂)은 북송의 학자인 범중엄의 악양루기에 나오는 말로 “先天下之憂而憂, 後天下之樂而樂”이라 하여, 세상 사람들이 걱정하기 전에 먼저 걱정하고, 세상 사람들이 모두 즐거워한 뒤에 나중에 즐거워 하겠다는 뜻이다. 모든 공직자와 사회 지도층, 우리 군민 모두가 늘 명심하고 실천한다면 「군민 모두가 행복한 순창」에 한층 다가서는 경구가 될 것이라 기대합니다. (2020년 1월 2일 신년사 中) 사진 이삼례 -2020년 1월 1일-
- 담당부서 : 기획예산실
- 작성일 : 2020-01-02